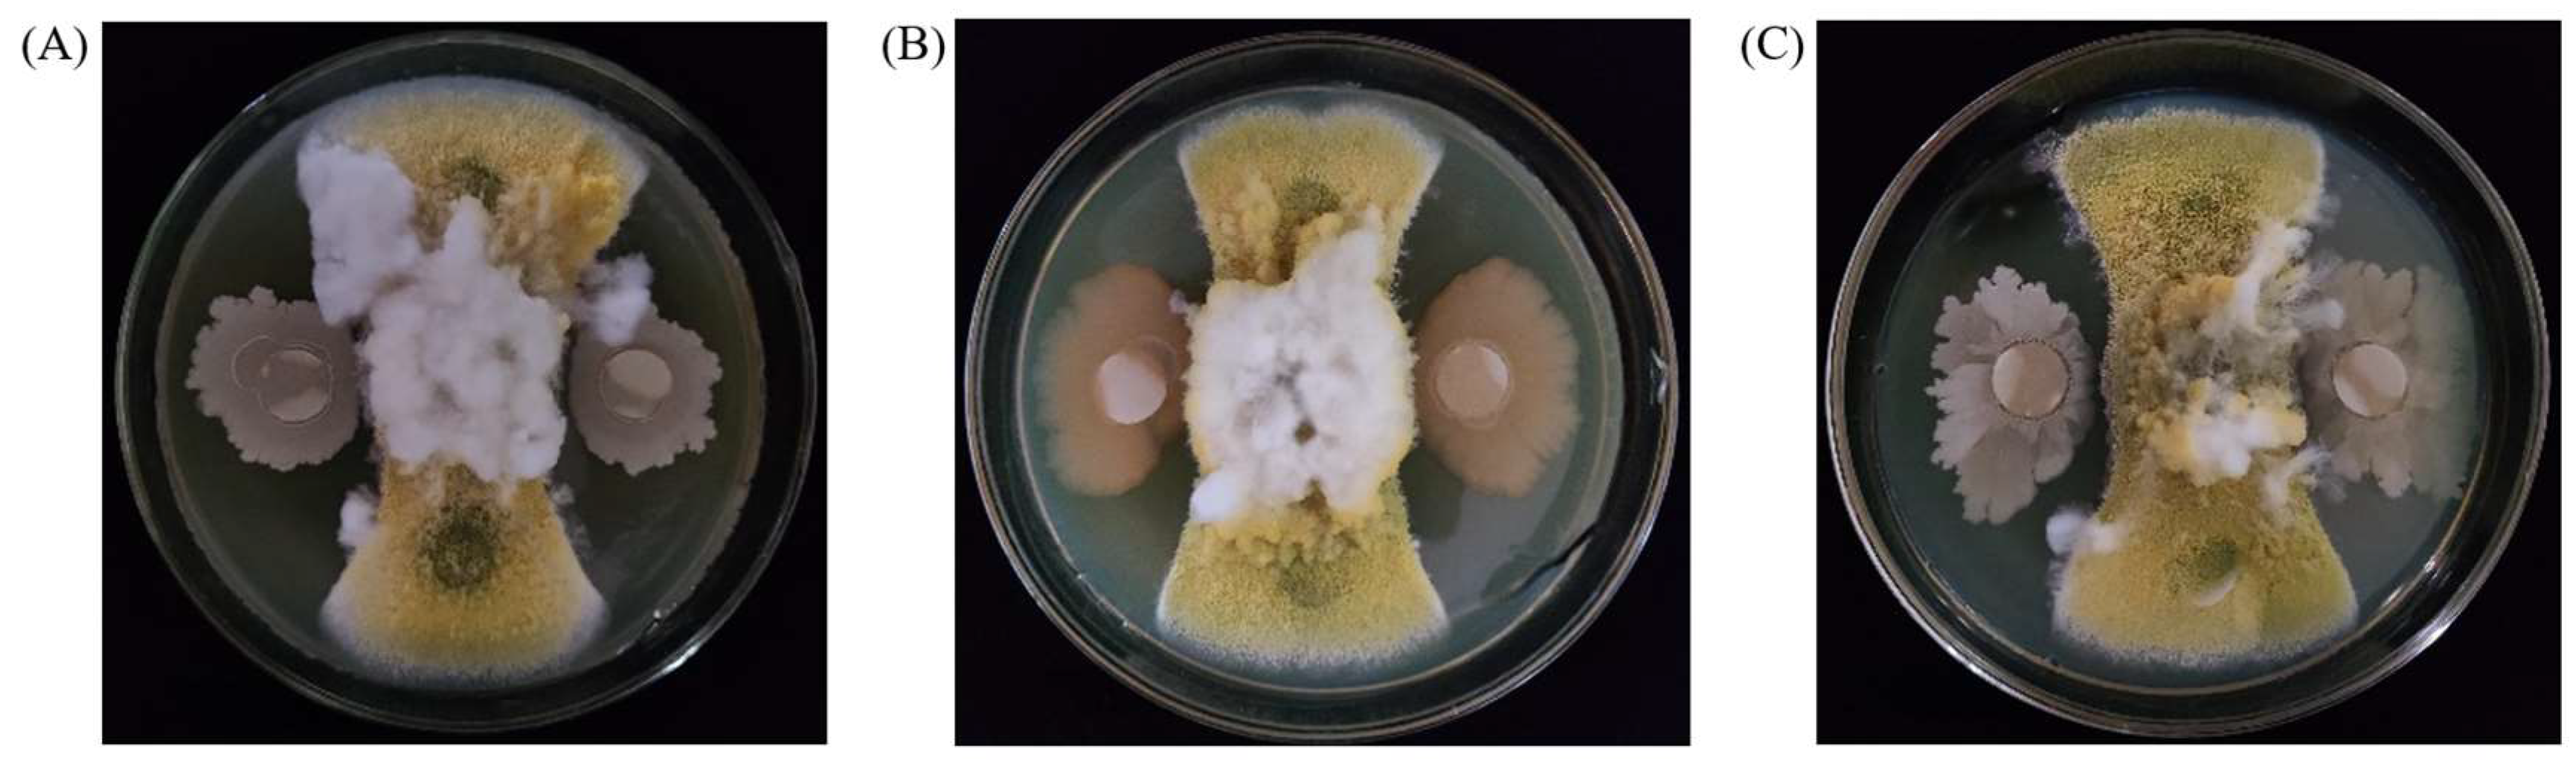
Toxins 15 00308 g001

Biocontrol Capabilities of Bacillus subtilis E11 against Aspergillus flavus In Vitro and for Dried Red Chili (Capsicum annuum L.)
Abstract
1. Introduction
2. Results
2.1. Screening of Strains with Biological Antagonistic Ability to A. flavus
2.2. The Abilities of B. subtilis E11, B. subtilis V1J1, and B. subtilis 9932 to Remove AFB1
2.3. The Biodegradation Ability of AFB1 by Culture Supernatant, Cells, and Cell Lysates
2.4. The Effects of B. subtilis E11 on aflR, aflS, and aflD Key Genes for AFB1 Production
2.5. The Ultrastructural Changes of B. subtilis E11 and A. flavus
2.6. The Potential of B. subtilis E11 as a Natural Food Preservative for Dried Red Chili
3. Discussion
4. Materials and Methods
4.1. Fungal and Bacterial Strains
4.2. Preparation of Spore Suspension
4.3. Screening of Strains with Resistance to A. flavus
4.4. Ability of the Selected Strains to Degrade AFB1
4.5. Determination of Growth Curves of B. subtilis E11, B. subtilis 9932, and B. subtilis V1J1
4.6. AFB1 Biodegradation by Culture Supernatant, Cells, and Cell Lysates
4.7. The Effects of B. subtilis E11 Culture Supernant on the Expression Levels of Genes Associated with AFB1 Production of A. flavus
4.7.1. Preparation of Mycelia Samples
4.7.2. Extraction of Total RNA
4.7.3. Synthesis of cDNA
4.7.4. Real-Time Quantitative Polymerase Chain Reaction (RT-qPCR)
4.8. SEM Analysis
4.9. The Biocontrol of B. subtilis E11 on Dried Red Chili
4.10. Statistical Analysis
Supplementary Materials
Author Contributions
Funding
Institutional Review Board Statement
Informed Consent Statement
Data Availability Statement
Conflicts of Interest
References
- Hernandez-Perez, T.; Gomez-Garcia, M.d.R.; Valverde, M.E.; Paredes-Lopez, O. Capsicum annuum (hot pepper): An ancient Latin-American crop with outstanding bioactive compounds and nutraceutical potential. A review. Compr. Rev. Food Sci. Food Saf. 2020, 19, 2972–2993. [Google Scholar] [CrossRef]
- Costa, J.; Rodriguez, R.; Garcia-Cela, E.; Medina, A.; Magan, N.; Lima, N.; Battilani, P.; Santos, C. Overview of Fungi and Mycotoxin Contamination in Capsicum Pepper and in Its Derivatives. Toxins 2019, 11, 27. [Google Scholar] [CrossRef]
- Rushing, B.R.; Selim, M.I. Aflatoxin B1: A review on metabolism, toxicity, occurrence in food, occupational exposure, and detoxification methods. Food Chem. Toxicol. 2019, 124, 81–100. [Google Scholar] [CrossRef]
- Rajendran, S.; Shunmugam, G.; Mallikarjunan, K.; Paranidharan, V.; Venugopal, A.P. Prevalence of aflatoxin contamination in red chilli pepper (Capsicum annuum L.) from India. Int. J. Food Sci. Technol. 2022, 57, 2185–2194. [Google Scholar] [CrossRef]
- European Commission. Commission Regulation (EC) No 1881/2006 Setting Maximum Levels for Certain Contaminants in Foodstuffs. Off. J. Eur. Union 2006, 364, 5–24. [Google Scholar]
- Watanakij, N.; Visessanguan, W.; Petchkongkaew, A. Aflatoxin B-1-degrading activity fromBacillus subtilisBCC 42005 isolated from fermented cereal products. Food Addit. Contam. Part A-Chem. Anal. Control Expo. Risk Assess. 2020, 37, 1579–1589. [Google Scholar] [CrossRef]
- Benkerroum, N. Aflatoxins: Producing-Molds, Structure, Health Issues and Incidence in Southeast Asian and Sub-Saharan African Countries. Int. J. Environ. Res. Public Health 2020, 17, 1215. [Google Scholar] [CrossRef]
- Chen, T.; Liu, J.; Li, Y.; Wei, S. Burden of Disease Associated with Dietary Exposure to Aflatoxins in China in 2020. Nutrients 2022, 14, 1027. [Google Scholar] [CrossRef]
- Xuan, Z.; Ye, J.; Zhang, B.; Li, L.; Wu, Y.; Wang, S. An Automated and High-Throughput Immunoaffinity Magnetic Bead-Based Sample Clean-Up Platform for the Determination of Aflatoxins in Grains and Oils Using UPLC-FLD. Toxins 2019, 11, 583. [Google Scholar] [CrossRef]
- Chitarrini, G.; Nobili, C.; Pinzari, F.; Antonini, A.; De Rossi, P.; Del Fiore, A.; Procacci, S.; Tolaini, V.; Scala, V.; Scarpari, M.; et al. Buckwheat achenes antioxidant profile modulates Aspergillus flavus growth and aflatoxin production. Int. J. Food Microbiol. 2014, 189, 1–10. [Google Scholar] [CrossRef]
- Marchese, S.; Polo, A.; Ariano, A.; Velotto, S.; Costantini, S.; Severino, L. Aflatoxin B1 and M1: Biological Properties and Their Involvement in Cancer Development. Toxins 2018, 10, 214. [Google Scholar] [CrossRef] [PubMed]
- Limaye, A.; Yu, R.-C.; Chou, C.-C.; Liu, J.-R.; Cheng, K.-C. Protective and Detoxifying Effects Conferred by Dietary Selenium and Curcumin against AFB1-Mediated Toxicity in Livestock: A Review. Toxins 2018, 10, 25. [Google Scholar] [CrossRef]
- Benkerroum, N. Chronic and Acute Toxicities of Aflatoxins: Mechanisms of Action. Int. J. Environ. Res. Public Health 2020, 17, 423. [Google Scholar] [CrossRef]
- Kumar, A.; Pathak, H.; Bhadauria, S.; Sudan, J. Aflatoxin contamination in food crops: Causes, detection, and management: A review. Food Prod. Process. Nutr. 2021, 3, 1–9. [Google Scholar] [CrossRef]
- Tumukunde, E.; Xie, R.; Wang, S.H. Updates on the Functions and Molecular Mechanisms of the Genes Involved in Aspergillus flavus Development and Biosynthesis of Aflatoxins. J. Fungi. 2021, 7, 666. [Google Scholar] [CrossRef]
- Liao, J.; He, Z.; Xia, Y.; Lei, Y.; Liao, B. A review on biosynthesis and genetic regulation of aflatoxin production by major Aspergillus fungi. Oil Crop Sci. 2020, 5, 166–173. [Google Scholar] [CrossRef]
- Caceres, I.; Al Khoury, A.; El Khoury, R.; Lorber, S.; Oswald, I.; El Khoury, A.; Atoui, A.; Puel, O.; Bailly, J.-D. Aflatoxin Biosynthesis and Genetic Regulation: A Review. Toxins 2020, 12, 150. [Google Scholar] [CrossRef] [PubMed]
- Pandey, M.K.; Kumar, R.; Pandey, A.K.; Soni, P.; Gangurde, S.S.; Sudini, H.K.; Fountain, J.C.; Liao, B.S.; Desmae, H.; Okori, P.; et al. Mitigating Aflatoxin Contamination in Groundnut through A Combination of Genetic Resistance and Post-Harvest Management Practices. Toxins 2019, 11, 315. [Google Scholar] [CrossRef]
- Gil-Serna, J.; Vazquez, C.; Patino, B. Genetic regulation of aflatoxin, ochratoxin A, trichothecene, and fumonisin biosynthesis: A review. Int. Microbiol. 2020, 23, 89–96. [Google Scholar] [CrossRef]
- Peles, F.; Sipos, P.; Kovacs, S.; Gyori, Z.; Pocsi, I.; Pusztahelyi, T. Biological Control and Mitigation of Aflatoxin Contamination in Commodities. Toxins 2021, 13, 104. [Google Scholar] [CrossRef]
- Zabiulla, I.; Malathi, V.; Swamy, H.V.L.N.; Naik, J.; Pineda, L.; Han, Y. The Efficacy of a Smectite-Based Mycotoxin Binder in Reducing Aflatoxin B-1 Toxicity on Performance, Health and Histopathology of Broiler Chickens. Toxins 2021, 13, 856. [Google Scholar] [CrossRef] [PubMed]
- Ayob, O.; Hussain, P.R.; Naqash, F.; Riyaz, L.; Kausar, T.; Joshi, S.; Azad, Z.R.A.A. Aflatoxins: Occurrence in red chilli and control by gamma irradiation. Int. J. Food Sci. Technol. 2022, 57, 2149–2158. [Google Scholar] [CrossRef]
- Li, S.; Muhammad, I.; Yu, H.; Sun, X.; Zhang, X. Detection of Aflatoxin adducts as potential markers and the role of curcumin in alleviating AFB1-induced liver damage in chickens. Ecotoxicol. Environ. Saf. 2019, 176, 137–145. [Google Scholar] [CrossRef] [PubMed]
- Shabeer, S.; Asad, S.; Jamal, A.; Ali, A. Aflatoxin Contamination, Its Impact and Management Strategies: An Updated Review. Toxins 2022, 14, 307. [Google Scholar] [CrossRef]
- Eshelli, M.; Harvey, L.; Edrada-Ebel, R.; McNeil, B. Metabolomics of the Bio-Degradation Process of Aflatoxin B1 by Actinomycetes at an Initial pH of 6.0. Toxins 2015, 7, 439–456. [Google Scholar] [CrossRef] [PubMed]
- Ali, S.; Hassan, M.; Essam, T.; Ibrahim, M.A.; Al-Amry, K. Biodegradation of aflatoxin by bacterial species isolated from poultry farms. Toxicon 2021, 195, 7–16. [Google Scholar] [CrossRef]
- Verheecke, C.; Liboz, T.; Mathieu, F. Microbial degradation of aflatoxin B1: Current status and future advances. Int. J. Food Microbiol. 2016, 237, 1–9. [Google Scholar] [CrossRef]
- Suresh, G.; Cabezudo, I.; Pulicharla, R.; Cuprys, A.; Rouissi, T.; Brar, S.K. Biodegradation of aflatoxin B-1 with cell-free extracts of Trametes versicolor and Bacillus subtilis. Res. Vet. Sci. 2020, 133, 85–91. [Google Scholar] [CrossRef]
- Cai, M.; Qian, Y.; Chen, N.; Ling, T.; Wang, J.; Jiang, H.; Wang, X.; Qi, K.; Zhou, Y. Detoxification of aflatoxin B1 by Stenotrophomonas sp. CW117 and characterization the thermophilic degradation process. Environ. Pollut. 2020, 261, 114178. [Google Scholar] [CrossRef]
- Yue, X.; Ren, X.; Fu, J.; Wei, N.; Altomare, C.; Haidukowski, M.; Logrieco, A.F.; Zhang, Q.; Li, P. Characterization and mechanism of aflatoxin degradation by a novel strain of Trichoderma reesei CGMCC3.5218. Front. Microbiol. 2022, 13, 1003039. [Google Scholar] [CrossRef]
- Zhao, L.H.; Guan, S.; Gao, X.; Ma, Q.G.; Lei, Y.P.; Bai, X.M.; Ji, C. Preparation, purification and characteristics of an aflatoxin degradation enzyme from Myxococcus fulvus ANSM068. J. Appl. Microbiol. 2011, 110, 147–155. [Google Scholar] [CrossRef] [PubMed]
- Zhang, X.; Al-Dossary, A.; Hussain, M.; Setlow, P.; Li, J. Applications of Bacillus subtilis Spores in Biotechnology and Advanced Materials. Appl. Environ. Microbiol. 2020, 86, e01096-20. [Google Scholar] [CrossRef] [PubMed]
- Raman, J.; Kim, J.-S.; Choi, K.R.; Eun, H.; Yang, D.; Ko, Y.-J.; Kim, S.-J. Application of Lactic Acid Bacteria (LAB) in Sustainable Agriculture: Advantages and Limitations. Int. J. Mol. Sci. 2022, 23, 7784. [Google Scholar] [CrossRef] [PubMed]
- Chen, Y.-H.; Lee, P.-C.; Huang, T.-P. Biological Control of Collar Rot on Passion Fruits Via Induction of Apoptosis in the Collar Rot Pathogen by Bacillus subtilis. Phytopathology 2021, 111, 627–638. [Google Scholar] [CrossRef] [PubMed]
- De Simone, N.; Capozzi, V.; de Chiara, M.L.V.; Amodio, M.L.; Brahimi, S.; Colelli, G.; Drider, D.; Spano, G.; Russo, P. Screening of Lactic Acid Bacteria for the Bio-Control of Botrytis cinerea and the Potential of Lactiplantibacillus plantarum for Eco-Friendly Preservation of Fresh-Cut Kiwifruit. Microorganisms 2021, 9, 773. [Google Scholar] [CrossRef] [PubMed]
- Ren, X.; Zhang, Q.; Zhang, W.; Mao, J.; Li, P. Control of Aflatoxigenic Molds by Antagonistic Microorganisms: Inhibitory Behaviors, Bioactive Compounds, Related Mechanisms, and Influencing Factors. Toxins 2020, 12, 24. [Google Scholar] [CrossRef]
- Zhao, Y.; Zhang, C.; Folly, Y.M.E.; Chang, J.; Wang, Y.; Zhou, L.; Zhang, H.; Liu, Y. Morphological and Transcriptomic Analysis of the Inhibitory Effects of Lactobacillus plantarum on Aspergillus flavus Growth and Aflatoxin Production. Toxins 2019, 11, 636. [Google Scholar] [CrossRef]
- Guimaraes, A.; Santiago, A.; Teixeira, J.A.; Venancio, A.; Abrunhosa, L. Anti-aflatoxigenic effect of organic acids produced by &ITL actobacillus plantarum &IT. Int. J. Food Microbiol. 2018, 264, 31–38. [Google Scholar] [CrossRef]
- Farzaneh, M.; Shi, Z.-Q.; Ahmadzadeh, M.; Hu, L.-B.; Ghassempour, A. Inhibition of the Aspergillus flavus Growth and Aflatoxin B1 Contamination on Pistachio Nut by Fengycin and Surfactin-Producing Bacillus subtilis UTBSP1. Plant Pathol. J. 2016, 32, 209–215. [Google Scholar] [CrossRef]
- Awuchi, C.G.; Ondari, E.N.; Ogbonna, C.U.; Upadhyay, A.K.; Baran, K.; Okpala, C.O.R.; Korzeniowska, M.; Guine, R.P.F. Mycotoxins Affecting Animals, Foods, Humans, and Plants: Types, Occurrence, Toxicities, Action Mechanisms, Prevention, and Detoxification Strategies—A Revisit. Foods 2021, 10, 1279. [Google Scholar] [CrossRef] [PubMed]
- Zhu, Y.; Xu, Y.; Yang, Q. Antifungal properties and AFB (1) detoxification activity of a new strain of Lactobacillus plantarum. J. Hazard. Mater. 2021, 414, 125569. [Google Scholar] [CrossRef] [PubMed]
- Boukaew, S.; Prasertsan, P.; Mahasawat, P.; Sriyatep, T.; Petlamul, W. Efficacy of the antifungal metabolites of Streptomyces philanthi RL-1-178 on aflatoxin degradation with its application to prevent aflatoxigenic fungi in stored maize grains and identification of the bioactive compound. World J. Microbiol. Biotechnol. 2023, 39, 1–12. [Google Scholar] [CrossRef] [PubMed]
- Li, B.; Wang, Z.; Yang, G.; Huang, S.; Liao, S.; Chen, K.; Du, M.; Zalan, Z.; Hegyi, F.; Kan, J. Biocontrol potential of 1-pentanal emitted from lactic acid bacteria strains against Aspergillus flavus in red pepper (Capsicum annuum L.). Food Control 2022, 142, 109261. [Google Scholar] [CrossRef]
- Habschied, K.; Krstanovic, V.; Zdunic, Z.; Babic, J.; Mastanjevic, K.; Saric, G.K. Mycotoxins Biocontrol Methods for Healthier Crops and Stored Products. J. Fungi. 2021, 7, 348. [Google Scholar] [CrossRef] [PubMed]
- Wu, Q.; Li, H.; Wang, S.; Zhang, Z.; Zhang, Z.; Jin, T.; Hu, X.; Zeng, G. Differential Expression of Genes Related to Growth and Aflatoxin Synthesis in Aspergillus flavus When Inhibited by Bacillus velezensis Strain B2. Foods 2022, 11, 3620. [Google Scholar] [CrossRef]
- Siahmoshteh, F.; Hamidi-Esfahani, Z.; Spadaro, D.; Shams-Ghahfarokhi, M.; Razzaghi-Abyaneh, M. Unraveling the mode of antifungal action of Bacillus subtilis and Bacillus amyloliquefaciens as potential biocontrol agents against aflatoxigenic Aspergillus parasiticus. Food Control 2018, 89, 300–307. [Google Scholar] [CrossRef]
- Jaibangyang, S.; Nasanit, R.; Limtong, S. Biological control of aflatoxin-producing Aspergillus flavus by volatile organic compound-producing antagonistic yeasts. Biocontrol 2020, 65, 377–386. [Google Scholar] [CrossRef]
- Bertuzzi, T.; Leni, G.; Bulla, G.; Giorni, P. Reduction of Mycotoxigenic Fungi Growth and Their Mycotoxin Production by Bacillus subtilis QST 713. Toxins 2022, 14, 797. [Google Scholar] [CrossRef]
- Shu, X.; Wang, Y.; Zhou, Q.; Li, M.; Hu, H.; Ma, Y.; Chen, X.; Ni, J.; Zhao, W.; Huang, S.; et al. Biological Degradation of Aflatoxin B-1 by Cell-Free Extracts of Bacillus velezensis DY3108 with Broad PH Stability and Excellent Thermostability. Toxins 2018, 10, 330. [Google Scholar] [CrossRef]
- Fang, Q.a.; Du, M.; Chen, J.; Liu, T.; Zheng, Y.; Liao, Z.; Zhong, Q.; Wang, L.; Fang, X.; Wang, J. Degradation and Detoxification of Aflatoxin B1 by Tea-Derived Aspergillus niger RAF106. Toxins 2020, 12, 777. [Google Scholar] [CrossRef]
- Petchkongkaew, A.; Taillandier, P.; Gasaluck, P.; Lebrihi, A. Isolation of Bacillus spp. from Thai fermented soybean (Thua-nao): Screening for aflatoxin B-1 and ochratoxin A detoxification. J. Appl. Microbiol. 2008, 104, 1495–1502. [Google Scholar] [CrossRef] [PubMed]
- Chen, G.; Fang, Q.a.; Liao, Z.; Xu, C.; Liang, Z.; Liu, T.; Zhong, Q.; Wang, L.; Fang, X.; Wang, J. Detoxification of Aflatoxin B1 by a Potential Probiotic Bacillus amyloliquefaciens WF2020. Front. Microbiol. 2022, 13, 891091. [Google Scholar] [CrossRef] [PubMed]
- Xue, G.; Qu, Y.; Wu, D.; Huang, S.; Che, Y.; Yu, J.; Song, P. Biodegradation of Aflatoxin B-1 in the Baijiu Brewing Process by Bacillus cereus. Toxins 2023, 15, 65. [Google Scholar] [CrossRef] [PubMed]
- Yan, Y.; Zhang, X.; Chen, H.; Huang, W.; Jiang, H.; Wang, C.; Xiao, Z.; Zhang, Y.; Xu, J. Isolation and Aflatoxin B1-Degradation Characteristics of a Microbacterium proteolyticum B204 Strain from Bovine Faeces. Toxins 2022, 14, 525. [Google Scholar] [CrossRef]
- Li, S.; Xu, X.; Zhao, T.; Ma, J.; Zhao, L.; Song, Q.; Sun, W. Screening of Bacillus velezensis E2 and the Inhibitory Effect of Its Antifungal Substances on Aspergillus flavus. Foods 2022, 11, 140. [Google Scholar] [CrossRef]
- Zhao, H.B.; Shao, D.Y.; Jiang, C.M.; Shi, J.L.; Li, Q.; Huang, Q.S.; Rajoka, M.S.R.; Yang, H.; Jin, M.L. Biological activity of lipopeptides from Bacillus. Appl. Microbiol. Biotechnol. 2017, 101, 5951–5960. [Google Scholar] [CrossRef]
- Kumar, V.; Bahuguna, A.; Lee, J.S.; Sood, A.; Han, S.S.; Chun, H.S.; Kim, M. Degradation mechanism of aflatoxin B1 and aflatoxin G1 by salt tolerant Bacillus albus YUN5 isolated from ‘doenjang’, a traditional Korean food. Food Res. Int. 2023, 165, 112479. [Google Scholar] [CrossRef]
- Xing, F.; Wang, L.; Liu, X.; Selvaraj, J.N.; Wang, Y.; Zhao, Y.; Liu, Y. Aflatoxin B-1 inhibition in Aspergillus flavus by Aspergillus niger through down-regulating expression of major biosynthetic genes and AFB (1) degradation by atoxigenic A. flavus. Int. J. Food Microbiol. 2017, 256, 1–10. [Google Scholar] [CrossRef]
- Kong, Q.; Chi, C.; Yu, J.; Shan, S.; Li, Q.; Li, Q.; Guan, B.; Nierman, W.C.; Bennett, J.W. The inhibitory effect of Bacillus megaterium on aflatoxin and cyclopiazonic acid biosynthetic pathway gene expression in Aspergillus flavus. Appl. Microbiol. Biotechnol. 2014, 98, 5161–5172. [Google Scholar] [CrossRef] [PubMed]
- Verheecke, C.; Liboz, T.; Anson, P.; Diaz, R.; Mathieu, F. Reduction of aflatoxin production by Aspergillus flavus and Aspergillus parasiticus in interaction with Streptomyces. Microbiol.-Sgm 2015, 161, 967–972. [Google Scholar] [CrossRef]
- Zhao, Q.; Qiu, Y.; Wang, X.; Gu, Y.; Zhao, Y.; Wang, Y.; Yue, T.; Yuan, Y. Inhibitory Effects of Eurotium cristatum on Growth and Aflatoxin B-1 Biosynthesis in Aspergillus flavus. Front. Microbiol. 2020, 11, 921. [Google Scholar] [CrossRef] [PubMed]
- Skerker, J.M.; Pianalto, K.M.; Mondo, S.J.; Yang, K.; Arkin, A.P.; Keller, N.P.; Grigoriev, I.V.; Glass, N.L.L. Chromosome assembled and annotated genome sequence of Aspergillus flavus NRRL 3357. G3-Genes Genomes Genet. 2021, 11, jkab213. [Google Scholar] [CrossRef]
- Gilbert, M.K.; Mack, B.M.; Lebar, M.D.; Chang, P.-K.; Gross, S.R.; Sweany, R.R.; Cary, J.W.; Rajasekaran, K. Putative Core Transcription Factors Affecting Virulence in Aspergillus flavus during Infection of Maize. J. Fungi 2023, 9, 118. [Google Scholar] [CrossRef] [PubMed]
- Liu, Y.; Teng, K.; Wang, T.; Dong, E.; Zhang, M.; Tao, Y.; Zhong, J. Antimicrobial Bacillus velezensis HC6: Production of three kinds of lipopeptides and biocontrol potential in maize. J. Appl. Microbiol. 2020, 128, 242–254. [Google Scholar] [CrossRef]
- Shakeel, Q.; Lyu, A.; Zhang, J.; Wu, M.; Li, G.; Hsiang, T.; Yang, L. Biocontrol of Aspergillus flavus on Peanut Kernels Using Streptomyces yansingensis 3–10. Front. Microbiol. 2018, 9, 1049. [Google Scholar] [CrossRef] [PubMed]
- Dopazo, V.; Luz, C.; Manes, J.; Quiles, J.M.; Carbonell, R.; Calpe, J.; Meca, G. Bio-Preservative Potential of Microorganisms Isolated from Red Grape against Food Contaminant Fungi. Toxins 2021, 13, 412. [Google Scholar] [CrossRef]
- Shifa, H.; Tasneem, S.; Gopalakrishnan, C.; Velazhahan, R. Biological control of pre-harvest aflatoxin contamination in groundnut (Arachis hypogaea L.) with Bacillus subtilis G1. Arch. Phytopathol. Plant Prot. 2016, 49, 137–148. [Google Scholar] [CrossRef]
- Natarajan, S.; Balachandar, D.; Senthil, N.; Paranidharan, V. Interaction of water activity and temperature on growth, gene expression, and aflatoxin B-1 production in Aspergillus flavus on Indian senna (Cassia angustifolia Vahl.). Int. J. Food Microbiol. 2022, 361, 109457. [Google Scholar] [CrossRef]
- Zhang, Y.; Li, Z.; Lu, Y.; Zhang, J.; Sun, Y.; Zhou, J.; Tu, T.; Gong, W.; Sun, W.; Wang, Y. Characterization of Bacillus velezensis E2 with abilities to degrade ochratoxin A and biocontrol against Aspergillus westerdijkiae fc-1. Toxicon 2022, 216, 125–131. [Google Scholar] [CrossRef]
- Ju, S.; Cao, Z.; Wong, C.; Liu, Y.; Foda, M.F.; Zhang, Z.; Li, J. Isolation and Optimal Fermentation Condition of the Bacillus subtilis Subsp. natto Strain WTC016 for Nattokinase Production. Ferment. -Basel 2019, 5, 92. [Google Scholar] [CrossRef]
- Wang, L.; Huang, W.; Sha, Y.; Yin, H.; Liang, Y.; Wang, X.; Shen, Y.; Wu, X.; Wu, D.; Wang, J. Co-Cultivation of Two Bacillus Strains for Improved Cell Growth and Enzyme Production to Enhance the Degradation of Aflatoxin B-1. Toxins 2021, 13, 435. [Google Scholar] [CrossRef] [PubMed]
- Einloft, T.C.; de Oliveira, P.B.; Radunz, L.L.; Dionello, R.G. Biocontrol capabilities of three Bacillus isolates towards aflatoxin B1 producer A. flavus in vitro and on maize grains. Food Control 2021, 125, 107978. [Google Scholar] [CrossRef]

| Gene | Sequence (5′–3′) | Reference |
|---|---|---|
| β-tubulin | F: TCTTCATGGTTGGCTTCGCT | [61] |
| R: CTTGGGGTCGAACATCTGCT | ||
| aflR | F: GGCATCTCCCGGACCGAT | |
| R: TTGACAGGCAAGACCACGTTCGAT | ||
| aflS | F: TGGTGCGACCATATTTACA | |
| R: GGTTGGGTCACGAACTGTTT | ||
| aflD | F: ATGCTCCCGTCCTACTGTTT | |
| R: ATGTTGGTGATGGTGCTGAT |
Disclaimer/Publisher’s Note: The statements, opinions and data contained in all publications are solely those of the individual author(s) and contributor(s) and not of MDPI and/or the editor(s). MDPI and/or the editor(s) disclaim responsibility for any injury to people or property resulting from any ideas, methods, instructions or products referred to in the content. |
© 2023 by the authors. Licensee MDPI, Basel, Switzerland. This article is an open access article distributed under the terms and conditions of the Creative Commons Attribution (CC BY) license (https://creativecommons.org/licenses/by/4.0/).
Share and Cite
Yuan, S.; Wu, Y.; Jin, J.; Tong, S.; Zhang, L.; Cai, Y. Biocontrol Capabilities of Bacillus subtilis E11 against Aspergillus flavus In Vitro and for Dried Red Chili (Capsicum annuum L.). Toxins 2023, 15, 308. https://doi.org/10.3390/toxins15050308
Yuan S, Wu Y, Jin J, Tong S, Zhang L, Cai Y. Biocontrol Capabilities of Bacillus subtilis E11 against Aspergillus flavus In Vitro and for Dried Red Chili (Capsicum annuum L.). Toxins. 2023; 15(5):308. https://doi.org/10.3390/toxins15050308
Chicago/Turabian StyleYuan, Shenglan, Yongjun Wu, Jing Jin, Shuoqiu Tong, Lincheng Zhang, and Yafei Cai. 2023. "Biocontrol Capabilities of Bacillus subtilis E11 against Aspergillus flavus In Vitro and for Dried Red Chili (Capsicum annuum L.)" Toxins 15, no. 5: 308. https://doi.org/10.3390/toxins15050308
APA StyleYuan, S., Wu, Y., Jin, J., Tong, S., Zhang, L., & Cai, Y. (2023). Biocontrol Capabilities of Bacillus subtilis E11 against Aspergillus flavus In Vitro and for Dried Red Chili (Capsicum annuum L.). Toxins, 15(5), 308. https://doi.org/10.3390/toxins15050308

